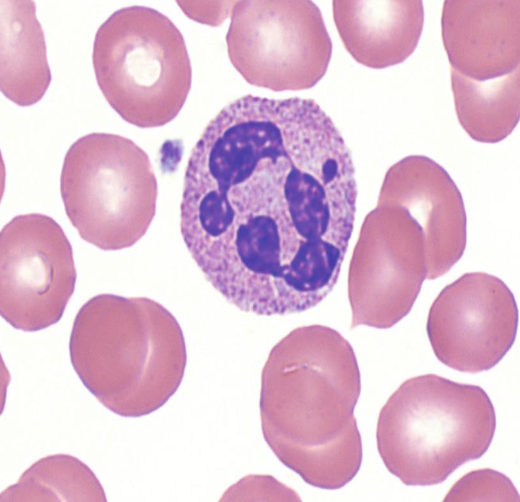
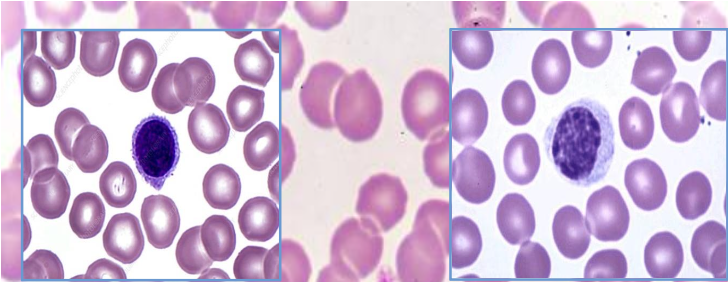
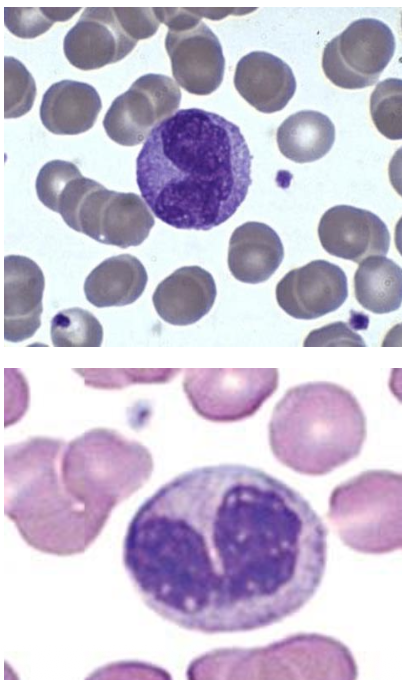
<p>????&nbsp;</p>

1/30
made with love
Name | Mastery | Learn | Test | Matching | Spaced | Call with Kai |
|---|
No analytics yet
Send a link to your students to track their progress
give an example of neutral stain ?
leishmans stain
give an example of polychromatic stain ( romanwsky stain )
giemsa and wright stain
??
Neutrophils
percentage ? diameter ? shape of nucleus ?
54-62%
12-15 µm
multilobed; segmented (2-5 segments)

???
Eosinophils
percentage ? diameter ? shape of nucleus ?
2-5%
12-15 µm
Bilobed (horseshoe-shaped)
????
Lymphocytes M & L
Normal percentage ? types ?
20_40 %
T- Lymphocytes.
B-Lymphocytes.
Natural killer cells.
????
Monocyte
percentage ? diameter ? shape of nucleus ?
2-10% of total WBCs
12-20 µm ( the largest )
Kidney-shaped

???
Lymph Node
Parenchyma of lymph node is formed of ?
cortex & medulla
The cortex is rich in ?
dark lymphoid follicles
The medulla contains ?
medullary cords

A ? B ? C ? D?
A___Capsule
B___subscapsular sinus
C___cortical follicles
D___medullary cords

???
Lymph Node
Mention the points
of identification?
Outer cortex: cortical follicles & sinuses.
Inner medulla: medullary cords and sinuses.

????
spleen
Parenchyma of the spleen
is formed of ?
white Pulp
and red Pulp
The white pulp shows ?
Central arteriole.

A ? B ? C ?
A___red pulp
B___white pulp
C___centeral arteriole and PALS

???
Spleen
Mention the points
of identification?
White pulps: (with central arterioles).
Red pulps: (with blood sinusoids).

???
Thymus gland
Each lobule has an ?
outer dark cortex and inner pale medulla.

A? B ? C ?
A___thymic lobule
B___outer cortex
C___inner medulla

????
thymus gland
Mention the points of
identification?
Thymic lobules: outer dark cortex & inner pale medulla.
Hassall’s corpuscles in the medulla.

????
palatine tonsil

A? B? C ?
A___tonsillar crypts
B___non keratinized stratified sq epith
C___lymphatic follicles
اقلب
يا رب تتجوز